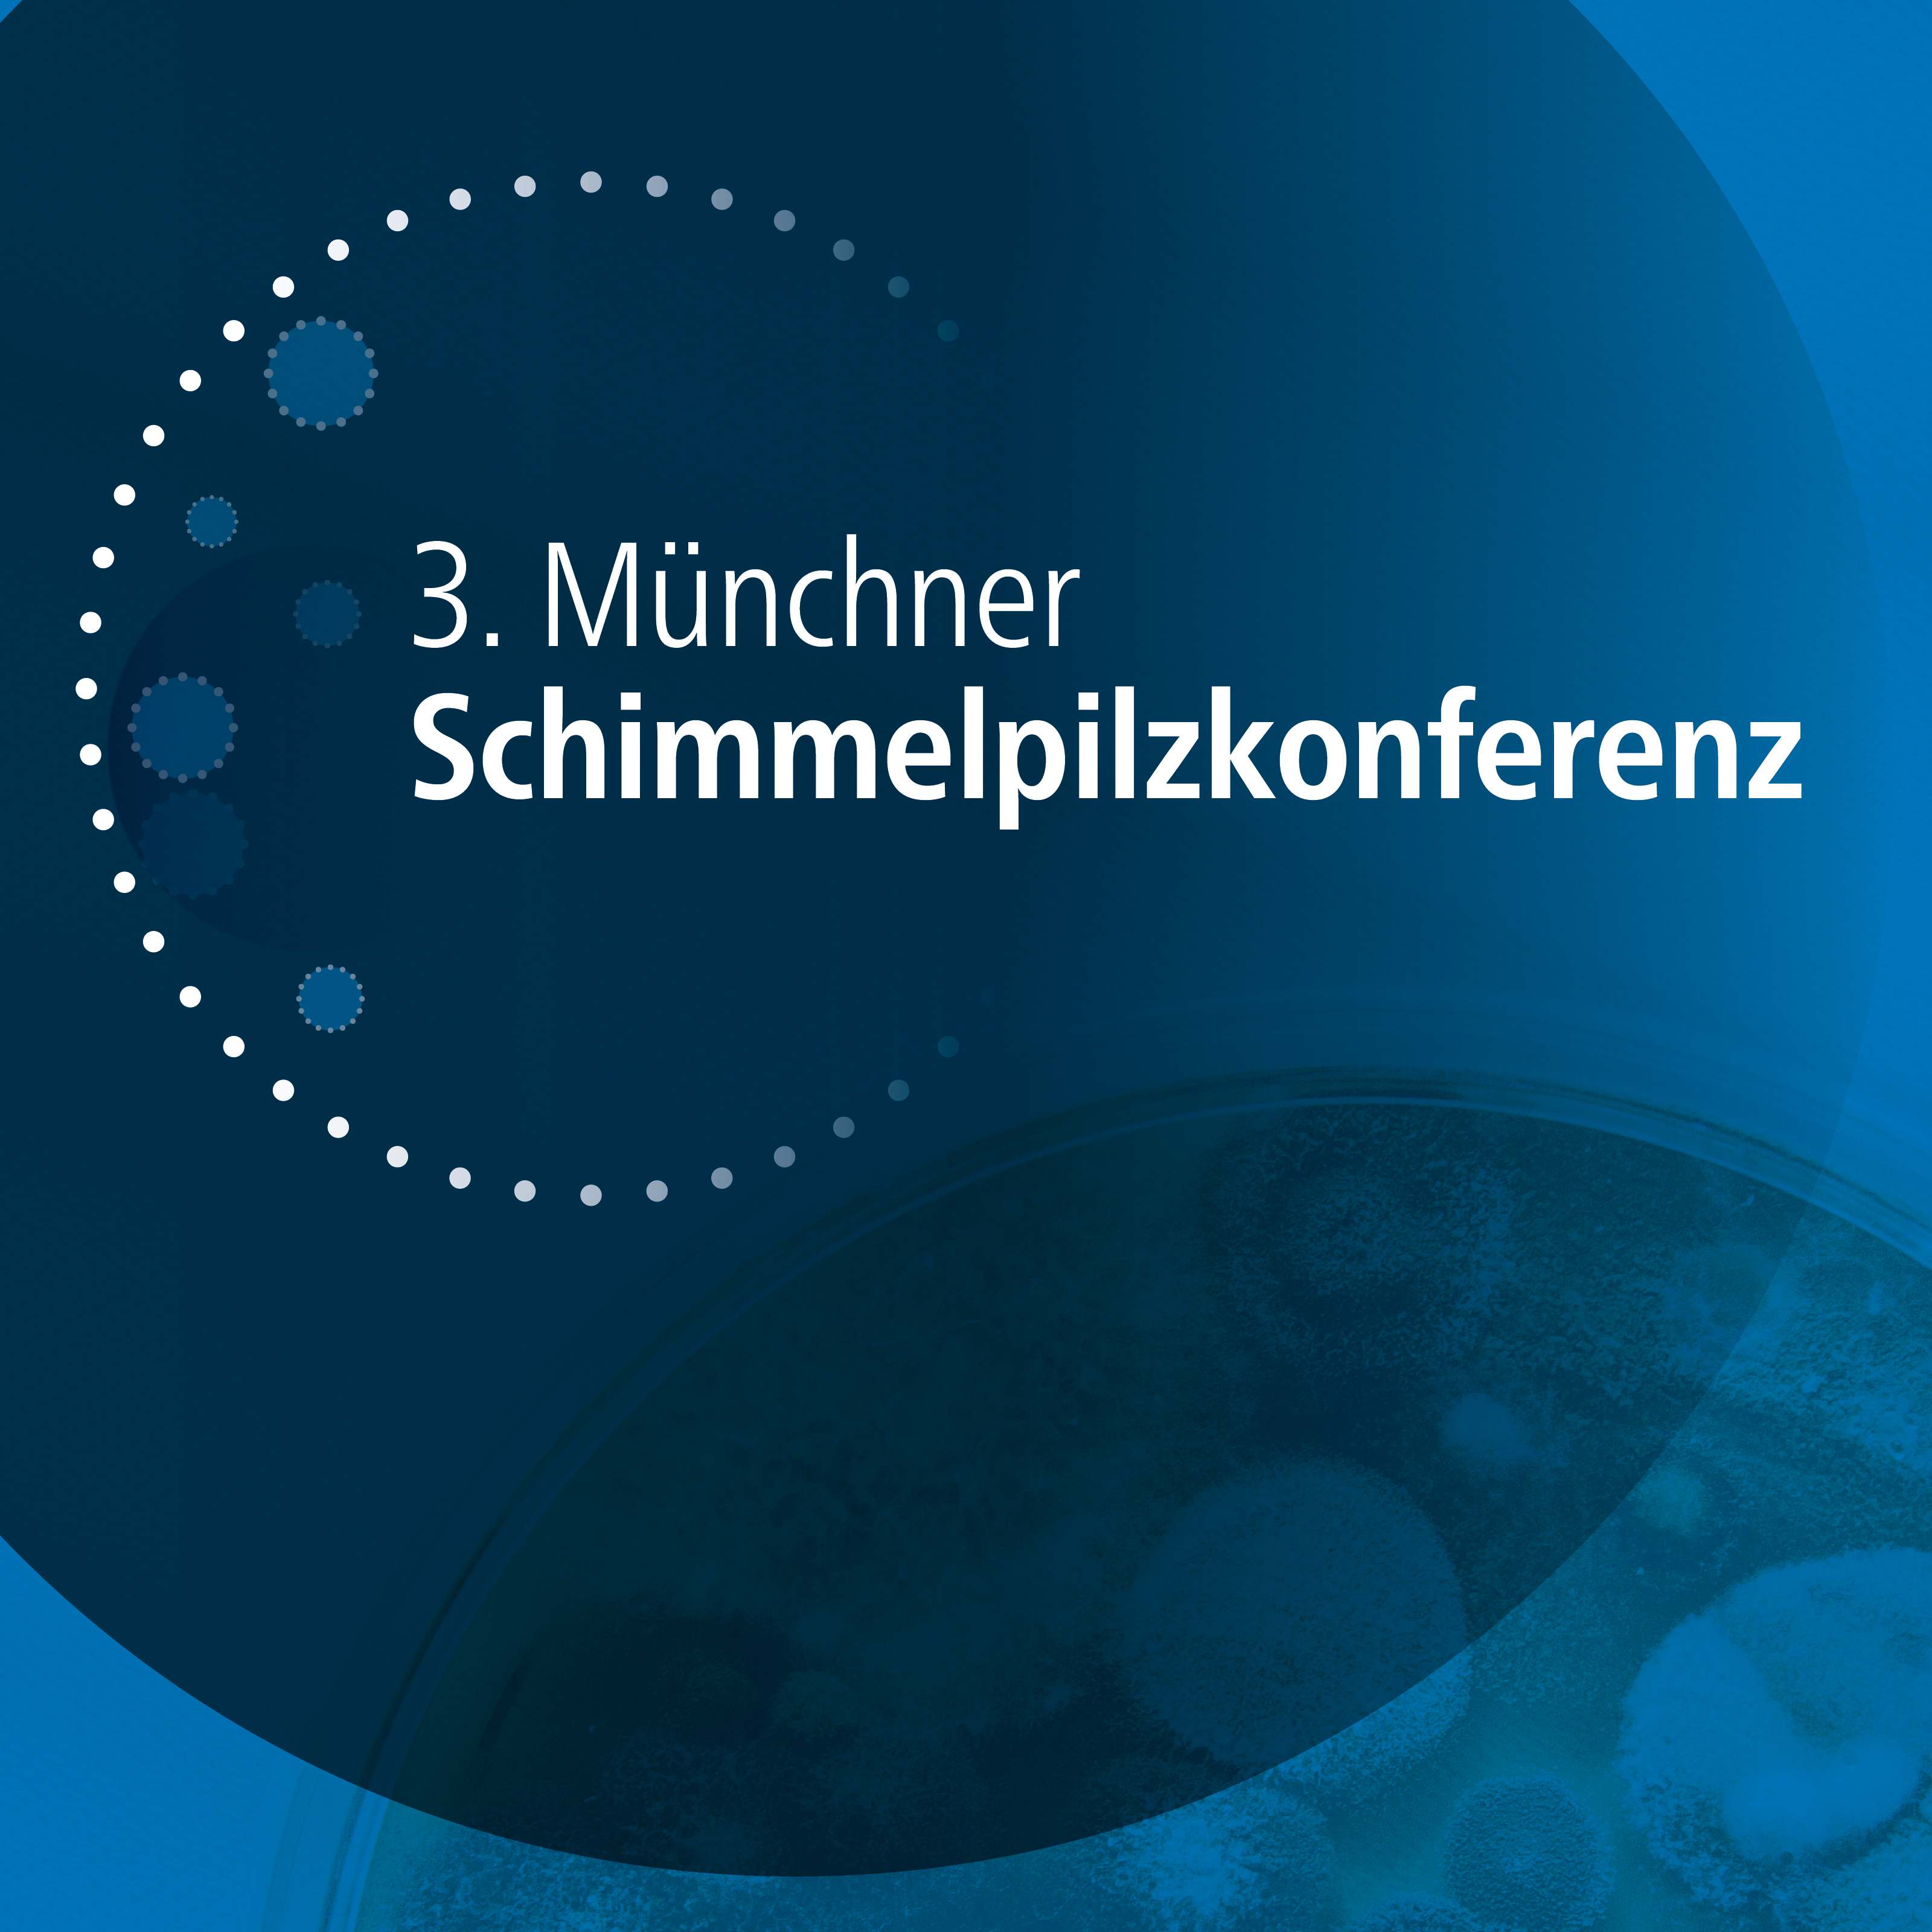
Course Image 3. Münchner Schimmelpilzkonferenz
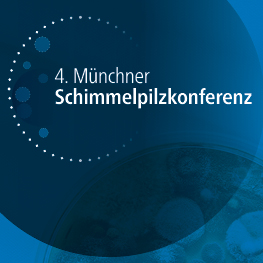
Course Image 4. Münchner Schimmelpilzkonferenz
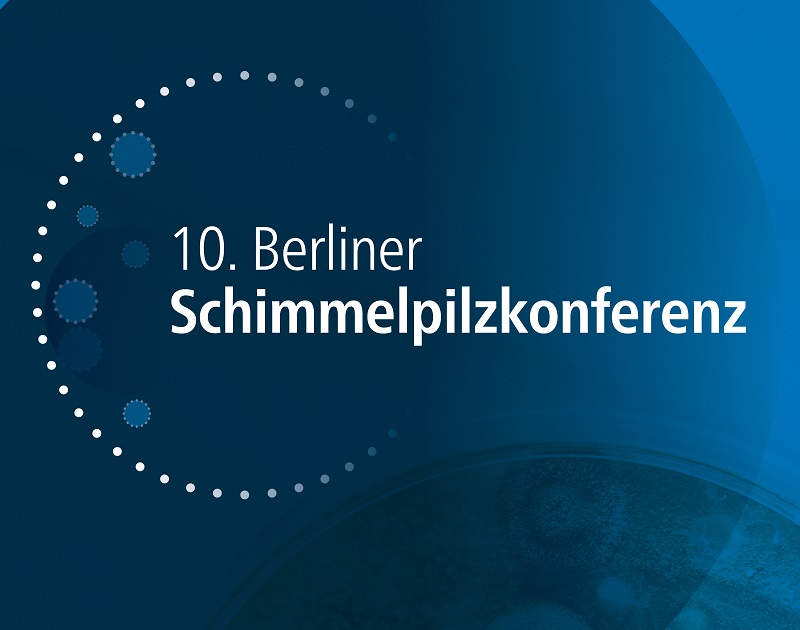
Course Image 10. Berliner Schimmelpilzkonferenz
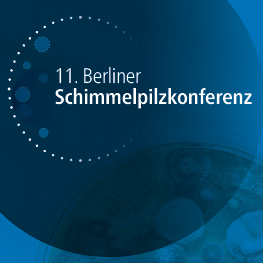
Course Image 11. Berliner Schimmelpilzkonferenz (24.03.2022)

- Trainer/in: Katharina Diel
- Trainer/in: Eric Naundorf
- Trainer/in: Tino Reiher
- Trainer/in: Malte von Lüttichau

- Trainer/in: Eric Naundorf
- Trainer/in: Tino Reiher
- Trainer/in: Malte von Lüttichau

- Trainer/in: Katharina Diel
- Trainer/in: Markus Langenbach

- Trainer/in: Nicole Borgmann
- Trainer/in: Tanja Buß
- Trainer/in: Lilian Kraft (Rudolf Müller)
- Trainer/in: Katharina Diel
- Trainer/in: Katharina Diel
- Trainer/in: Marcel Moser

7. Fachtagung bfb barrierefrei bauen
Hier geht es zur digitalen 7. Fachtagung "bfb barrierefrei bauen" inkl. virtueller Fachschau.
- Trainer/in: Ben-Micha Becker
- Trainer/in: Nicole Borgmann
- Trainer/in: Tanja Buß
- Trainer/in: Stephanie Dietel
- Trainer/in: Stephanie Dietel
- Trainer/in: Lisa Ensminger
- Trainer/in: Lilian Kraft (Rudolf Müller)
- Trainer/in: Lena Roppes
- Trainer/in: Jonas Spindler
- Trainer/in: Katharina Diel
- Trainer/in: Linda Wiese (Rudolf Müller)
- Trainer/in: Katharina Diel
- Trainer/in: Linda Wiese (Rudolf Müller)

- Trainer/in: Malte von Lüttichau

- Trainer/in: Eric Naundorf
- Trainer/in: Tino Reiher
- Trainer/in: Malte von Lüttichau

- Trainer/in: Eric Naundorf
- Trainer/in: Tino Reiher
- Trainer/in: Malte von Lüttichau

- Trainer/in: Nicole Borgmann
- Trainer/in: Lena Roppes

- Trainer/in: Katharina Diel




